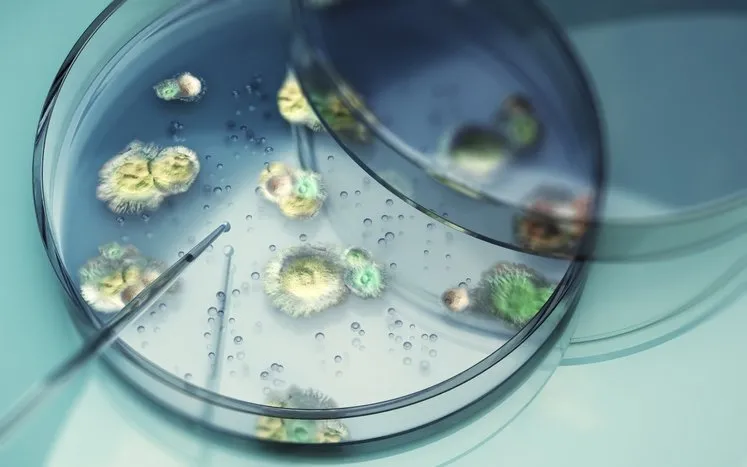

Bilim insanları, bu mantarın insanlara bulaşmasının mümkün olmadığını vurgulasa da, zombi örümceklerin ortaya çıkışı hem bilim dünyasında hem de halk arasında büyük merak uyandırdı.
ÖRÜMCEKLERİ ZOMBİYE ÇEVİREN MANTAR NASIL ÇALIŞIYOR?
Uzmanlara göre G. attenboroughii, örümceğin vücuduna tutunarak kan benzeri sıvısının dolaştığı boşluğu (hemocoel) istila ediyor. Daha sonra örümceğin dopamin seviyelerini değiştirerek davranışlarını kontrol altına alıyor. Normalde ağında saklanan örümcek, mantarın etkisiyle yuvasını terk ediyor ve açık alanda ölüme sürükleniyor.

Örümcek öldükten sonra mantar, vücudu antibiyotiklerle koruyor ve çürümesini engelliyor. Ardından yüksek nemli ortamlarda uzun beyaz saplar şeklinde meyve gövdeleri çıkararak sporlarını etrafa yayıyor. Böylece yeni örümcekler enfekte edilerek ölüm döngüsü sürüyor.
İLK KEZ BELGESEL ÇEKİMLERİNDE ORTAYA ÇIKTI
Bu korkutucu mantar ilk olarak 2021 yılında BBC'nin doğa belgeseli Winterwatch çekimleri sırasında Kuzey İrlanda'da fark edildi. Terk edilmiş bir barut deposunun tavanında bulunan örümceğin üzerinde beyaz, pamuksu bir tabaka göze çarpıyordu.

Araştırmayı yürüten Dr. Harry Evans ve ekibi, mantarın konak olarak "orb-weaving cave spider" adı verilen Metellina merianae türü mağara örümceğini kullandığını belirledi. Daha sonra aynı mantara, mağaralarda yaşayan bir diğer örümcek türü olan Meta menardi üzerinde de rastlandı.
Genetik analizler sonucunda bu parazitin daha önce tanımlanmamış bir tür olduğu anlaşıldı. Bilim insanları, doğa tarihine katkılarından dolayı mantara David Attenborough'nun adını verdi: Gibellula attenboroughii.
ZOMBİ ÖRÜMCEKLER DÜNYANIN FARKLI YERLERİNDE GÖRÜLDÜ
Keşiften bu yana zombi örümcek vakaları yalnızca İrlanda ile sınırlı kalmadı. Son yıllarda ABD'nin Minnesota ve New York eyaletlerinde, İngiltere'nin bahçelerinde ve mağaralarında, Çekya'nın bodrum katlarında ve hatta Rusya'nın şarap mahzenlerinde benzer örnekler rapor edildi.
Londra'da bir peyzaj ustası olan Gareth Jenkins, bir bahçe terasını sökerken pamuk yumağına benzeyen bir örümcek kolonisiyle karşılaştığını söyledi. Jenkins, "Bacakları kıvrılmış halde, sanki üzerime atlayacaklarmış gibi görünüyorlardı" diyerek yaşadığı korkuyu anlattı.
Benzer şekilde Rusya'nın Anapa kentinde yaşayan Simon Butenko, ailesinin mahzeninde "küflü üzümlere" benzeyen zombi örümcekler gördüğünü belirtti.
İNSANLARA BULAŞABİLİR Mİ?
Zombi örümceklerin akla getirdiği ilk soru, mantarın insanlara da bulaşma ihtimali. Popüler kültürde, özellikle Last of Us dizisinde mantarların insanları zombiye dönüştürmesi büyük ses getirmişti. Ancak bilim insanları bu türün insana bulaşmasının mümkün olmadığını söylüyor.
Danimarka Doğa Tarihi Müzesi'nden João Araújo, "İnsanları enfekte etmesi için milyonlarca yıl boyunca genetik değişim geçirmesi gerekir" diyerek endişeleri yatıştırdı.
DOĞADA KEŞFEDİLMEYİ BEKLEYEN MİLYONLARCA TÜR VAR
Bu keşif aynı zamanda mantar dünyasının ne kadar geniş ve gizemli olduğunu da ortaya koydu. Dr. Evans, mantar krallığının 10 ila 20 milyon tür barındırabileceğini, ancak şu ana kadar yalnızca yüzde 1'inin tanımlanabildiğini söyledi.

Yani, G. attenboroughii yalnızca buzdağının görünen kısmı olabilir. Araştırmacılara göre Britanya Adaları'ndaki mağaralarda daha pek çok bilinmeyen parazit mantar türü keşfedilmeyi bekliyor.
DOĞANIN KARANLIK YÜZÜ
Örümcekleri zombiye çeviren Gibellula attenboroughii, doğanın karanlık ve aynı zamanda büyüleyici yönlerinden biri. İnsanlar için bir tehdit oluşturmuyor olsa da, örümcekler üzerindeki etkisi hem bilimsel hem de görsel açıdan ürkütücü.

Bu mantar, doğadaki yaşam döngüsünün ne kadar acımasız olabileceğini hatırlatıyor. Aynı zamanda bizlere, daha keşfedilmeyi bekleyen milyonlarca mantar türünün olduğunu ve bu gizemli krallığın hâlâ sırlarla dolu olduğunu gösteriyor.
(Sabah)